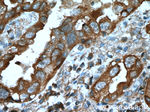
PKC iota Antibody in Immunohistochemistry (Paraffin) (IHC (P))

Search
Proteintech
PKC iota Polyclonal Antibody
{{$productOrderCtrl.translations['antibody.pdp.commerceCard.promotion.promotions']}}
{{$productOrderCtrl.translations['antibody.pdp.commerceCard.promotion.viewpromo']}}
{{$productOrderCtrl.translations['antibody.pdp.commerceCard.promotion.promocode']}}: {{promo.promoCode}} {{promo.promoTitle}} {{promo.promoDescription}}. {{$productOrderCtrl.translations['antibody.pdp.commerceCard.promotion.learnmore']}}
产品信息
13883-1-AP
种属反应
已发表种属
宿主/亚型
分类
类型
抗原
偶联物
形式
浓度
规格
纯化类型
保存液
内含物
保存条件
运输条件
产品详细信息
Immunogen sequence: SSLGLQDFD LLRVIGRGSY AKVLLVRLKK TDRIYAMKVV KKELVNDDED IDWVQTEKHV FEQASNHPFL VGLHSCFQTE SRLFFVIEYV NGGDLMFHMQ RQRKLPEEHA RFYSAEISLA LNYLHERGII YRDLKLDNVL LDSEGHIKLT DYGMCKEGLR PGDTTSTFCG TPNYIAPEIL RGEDYGFSVD WWALGVLMFE MMAGRSPFDI VGSSDNPDQN TEDYLFQVIL EKQIRIPRSM SVKAASVLKS FLNKDPKERL GCLPQTGFAD IQGHPFFRNV DWDMMEQKQV VPPFKPNISG EFGLDNFDSQ FTNERVQLTP DDDDIVRKID QSEFEGFEYI NPLLMSAEEC V (238-587 aa encoded by BC022016)
靶标信息
The PKC family of serine/threonine kinases, including PRKCI (PKC iota), is activated intracellularly by signal transduction pathways. In humans, at least 12 different PKC polypeptides have been identified. These isoforms differ in primary structure, tissue distribution, subcellular localization, mode of action in vitro, response to extracellular signals, and substrate specificity. PKC alpha, beta I, beta II and gamma form the conventional family; their activities are Ca2+- and phospholipid-dependent. The PKC family comprises at least eight members, which are differentially expressed and are involved in a wide variety of cellular processes. This protein kinase is calcium-independent and phospholipid-dependent. It is not activated by phorbolesters or diacylglycerol. This kinase can be recruited to vesicle tubular clusters (VTCs) by direct interaction with the small GTPase RAB2, where this kinase phosphorylates glyceraldehyde-3-phosphate dehydrogenase (GAPD/GAPDH) and plays a role in microtubule dynamics in the early secretory pathway. This kinase is found to be necessary for BCL-ABL-mediated resistance to drug-induced apoptosis and therefore protects leukemia cells against drug-induced apoptosis. There is a single exon pseudogene mapped on chromosome X.
仅用于科研。不用于诊断过程。未经明确授权不得转售。
生物信息学
蛋白别名: aPKC-lambda/iota; Atypical protein kinase C-lambda/iota; nPKC-iota; PKC iota; PRKC-lambda/iota; Protein kinase C iota type; unnamed protein product
基因别名: DXS1179E; nPKC-iota; PKCI; PRKCI
UniProt ID: (Human) P41743
Entrez Gene ID: (Human) 5584